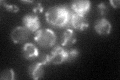
YGR132C
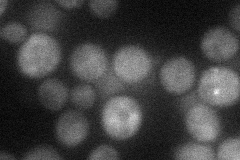
YGR132C
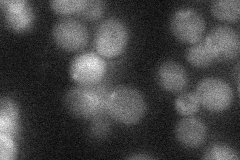
YGR132C
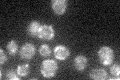
YGR132C

View description
Subunit of the prohibitin complex (Phb1p-Phb2p), a 1.2 MDa ring-shaped inner mitochondrial membrane chaperone that stabilizes newly synthesized proteins; determinant of replicative life span; involved in mitochondrial segregation
Localization:
Intensity:
Fold change:
Significance:
-
C’ GFP library in SD
mitochondria36.05 -
N' NOP1pr-GFP in SD

cytosol,punctate62.9254 -
N' TEF2pr-mCherry in SD
cytosol26.2722 -
N' NATIVEpr-GFP in SD
punctate24.8175 -
N' TEF2pr-VC and Cyto-VN in SD

#N/A0 -
C’ GFP library in SD+DTT

mitochondria35.750.99No -
C’ GFP library in SD+H2O2

mitochondria35.950.99No -
C’ GFP library in Starvation Media
mitochondria30.610.84No -
C’ GFP library on the background of Pup2-DaMP

N/A -
C’ GFP library on the background of CCT mutant

N/A0N/AYes
